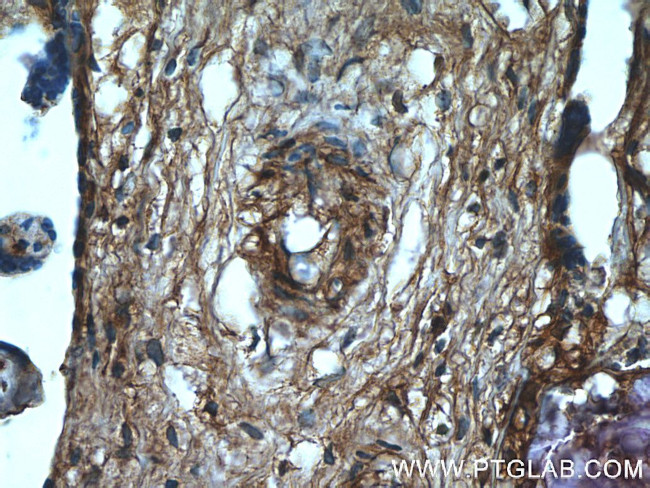
GNE Antibody in Immunohistochemistry (Paraffin) (IHC (P))
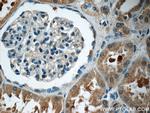
GNE Antibody in Immunohistochemistry (Paraffin) (IHC (P))

Search
Proteintech
GNE Polyclonal Antibody
{{$productOrderCtrl.translations['antibody.pdp.commerceCard.promotion.promotions']}}
{{$productOrderCtrl.translations['antibody.pdp.commerceCard.promotion.viewpromo']}}
{{$productOrderCtrl.translations['antibody.pdp.commerceCard.promotion.promocode']}}: {{promo.promoCode}} {{promo.promoTitle}} {{promo.promoDescription}}. {{$productOrderCtrl.translations['antibody.pdp.commerceCard.promotion.learnmore']}}
产品信息
25079-1-AP
种属反应
宿主/亚型
分类
类型
抗原
偶联物
形式
浓度
规格
纯化类型
保存液
内含物
保存条件
运输条件
产品详细信息
Immunogen sequence: SIDLQEPLQ KKFCFPPVKE NISQDIDHIL ETLSALAVDL GGTNLRVAIV SMKGEIVKKY TQFNPKTYEE RINLILQMCV EAAAEAVKLN CRILGVGIST GGRVNPREGI VLHSTKLIQE WNSVDLRTPL SDTLHLPVWV DNDGNCAALA ERKFGQGKGL ENFVTLITGT GIGGGIIHQH ELIHGSSFCA AELGHLVVSL DGPDCSCGSH GCIEAYASGM ALQREAKKLH DEDLLLVEGM SVPKDEAVGA LHLIQAAKLG NAKAQSILRT AGTALGLGVV NILHTMNPSL VILSGVLASH YIHIVKDVIR QQALSSVQDV DVVVSDLVDP ALLGAASMVL DYTTRRIY (376-722 aa encoded by BC121179)
靶标信息
GNE is a bifunctional enzyme that initiates and regulates the biosynthesis of N-acetylneuraminic acid (NeuAc), a precursor of sialic acids. It is a rate-limiting enzyme in the sialic acid biosynthetic pathway. Sialic acid modification of cell surface molecules is crucial for their function in many biologic processes, including cell adhesion and signal transduction. Differential sialylation of cell surface molecules is also implicated in the tumorigenicity and metastatic behavior of malignant cells.
仅用于科研。不用于诊断过程。未经明确授权不得转售。
生物信息学
蛋白别名: BA421H8.5; Bifunctional UDP-N-acetylglucosamine 2-epimerase/N-acetylmannosamine kinase; N-acylmannosamine kinase; UDP-GlcNAc-2-epimerase/ManAc kinase; UDP-N-acetylglucosamine 2-epimerase/N-acetylmannosamine kinase; unnamed protein product
基因别名: DMRV; GLCNE; GNE; IBM2; NM; THC12; Uae1
UniProt ID: (Human) Q9Y223
Entrez Gene ID: (Human) 10020